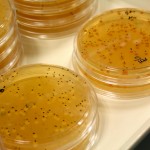
Levaduras del vino

Acabamos de conocer el desarrollo de un nuevo aparato que contribuirá a vendimiar las uvas en su punto óptimo de maduración, se trata de Multiplex, un dispositivo que realiza un análisis de la calidad de las uvas a pie de viña. En sólo unos minutos Multiplex puede ofrecer una medición sobre la cantidad de antocianina (pigmentos que otorgan el color a las uvas) y la cantidad de polifenoles (grupo de sustancias presentes sobre todo en los productos que se obtienen de algunas especies vegetales), sustancias que presentan una gran capacidad antioxidante y que ofrecen numerosos beneficios para la salud.
Ambos componentes influyen decisivamente tanto en la calidad como en el color del vino, recolectar las uvas en su momento óptimo de maduración y conocer el contenido de polifenoles y antocianinas, podría mejorar la calidad de los vinos a elaborar. Multiplex es un proyecto desarrollado por investigadores de la Universidad de la Rioja (UR) en colaboración con Force-A, una firma francesa que trabaja en la modernización de la agricultura, mejorar el rendimiento y la calidad de las producciones.
Multiplex realiza un análisis de la calidad de las uvas a pie de viña, se trata de un sensor óptico portátil que realiza la medición de las sustancias mencionadas a través de la emisión de espectros de luz (4 canales UV, azul, verde y rojo) que hacen reaccionar a las uvas, los datos son recogidos por el sensor dando resultados precisos sobre la cantidad de polifenoles, antocianinas y clorofila. Las mediciones realizadas permiten saber aproximadamente el tiempo que las uvas necesitan para estar en su punto óptimo de maduración y alcanzar el máximo nivel de las sustancias mencionadas.
El sensor óptico portátil se ha desarrollado tras 15 años de investigación y al parecer los resultados son muy satisfactorios, los investigadores del grupo de Viticultura de la Facultad de Ciencias de la Universidad de la Rioja han realizado mediciones con diferentes variedades de uvas, sea en racimos cortados o en racimos de la cepa, los resultados como decíamos, son rápidos y fiables, nada que ver con las técnicas de análisis físicas y químicas que se realizan habitualmente en los laboratorios.
El sistema Multiplex se puede utilizar de diferentes formas, los expertos indican que incluso se puede acoplar a un tractor y realizar las mediciones de calidad y maduración de todas las uvas de las cepas de forma instantánea, datos que además servirán para predecir el contenido total de los elementos mencionados dependiendo del momento en el que se realice la medición. Se podrá saber con bastante fiabilidad el contenido en polifenoles que tendrá el vino que se elabore.
Pero además, el sensor óptico portátil podría prevenir determinadas enfermedades que afectan a las plantas en un futuro. A través de El Correo podemos saber que los expertos indican que las investigaciones apuntan a instalar este dispositivo en las vendimiadoras para poder separar las uvas en el momento dependiendo de la cantidad y calidad de polifenoles y antocianinas que contengan, por lo que se podrá elaborar vino de mayor calidad, aunque también derivará en la clasificación de los vinos por categorías.
En poco tiempo las vendimiadoras podrían desarrollar dos funciones, vendimiar y separar por calidad. Sin duda, es un salto cualitativo en la elaboración de vino.